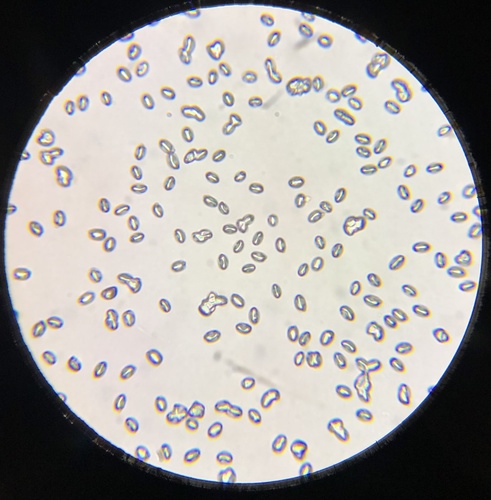

pseudoarmillariella ectypoides
Pseudoarmillariella ectypoides













+7
Der pseudoarmillariella ectypoides (Pseudoarmillariella ectypoides) ist ein Pilz .

Fungio
Schnelle und einfache Pilzsuche

Der pseudoarmillariella ectypoides (Pseudoarmillariella ectypoides) ist ein Pilz .
